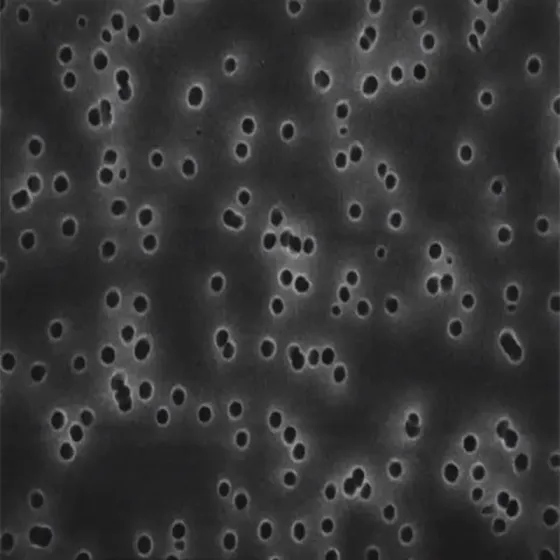

耗材配件产品详情
华元聚合物作为专业的实验室一站式采购平台,为您提供美国密理博 Millipore 的 GTTP02500 Isopore 滤膜。公司涵盖众多品牌正品,满足实验试剂、耗材等采购需求,让实验室采购更高效便捷。
基本信息
- 产品名称:Isopore 滤膜
- 别名:聚碳酸酯膜过滤器,孔径 0.22 μm
- 制造商 / 商品名称:Isopore™(Millipore,美国密理博)
- UNSPSC 代码:40161507
- eCl@ss:32031602
- NACRES:NB.24
- 包装规格:100 片 / 包
- 运输条件:常温运输
- 环保属性:Greener Alternative Product(环保替代产品),分类为 Re-engineered(重新设计);内盒和外盒由采用 ISCC 质量平衡方法分配的生物循环材料制成
- 滤器类型:筛选过滤
- 滤器编码:GTTP
物料与质量
- 物料:聚碳酸酯膜,普通滤膜,白色滤膜
- 无菌性:非无菌(non-sterile)
- 特点:亲水性(hydrophilic),非吸湿性,半透明(无需透明处理即可用于透射光显微镜),有棕色产品可选
产品参数
- 孔径:0.22 μm
- 孔隙率:13.8%
- 直径:25 mm
- 过滤器直径:25 mm
- 厚度:25 μm
- 重量萃取物:<1%
- 颜色:白色
- 折射率:n/D 1.6
- 基质:Isopore™
- 最高温度:140 °C
- 空气流速:0.007 L/min-cm²-psi
- 水流速:3.36 mL/min-cm²-psi(最大流速 / 1.0 psi);~16 mL/min-cm²(10 psi 时典型值)
- 泡点:≥5.2 bar(23°C 时,空气与水)
特点与优势
在华元聚合物采购的这款滤膜具有显著优势:
- 轨迹蚀刻的网式结构,颗粒保留在表面,简化计数和分析
- 孔径精确且一致,可按粒径准确分离样品
- 不染色,背景干扰低,提升观察清晰度
- 非吸湿性,干燥速度快,减少样品分析时间
- 光滑玻璃状表面,便于光学或电子显微镜观察;半透明材质适配透射光显微镜
应用领域
这款滤膜应用广泛,在华元聚合物官网采购后,可用于:
- 空气监测
- 落射荧光显微镜观察
- 趋化性测定(趋化研究)
- 生物测定
- 细胞学研究
- SEM 分析
- 无菌测试
- 微塑料分析
- 微塑料分析级水制备
其他说明
- 法律信息:Isopore 是德国达姆施塔特默克集团的商标
- 免责声明:高压灭菌后可能会降低流速
华元聚合物作为可靠的试剂耗材采购平台,除该款滤膜外,还提供赛默飞、安捷伦等众多品牌正品,支持危化品合规供应,免费咨询即可享受专业一站式采购服务。
立即联系华元聚合物
获取专业定制的实验室仪器耗材/化学试剂采购方案。